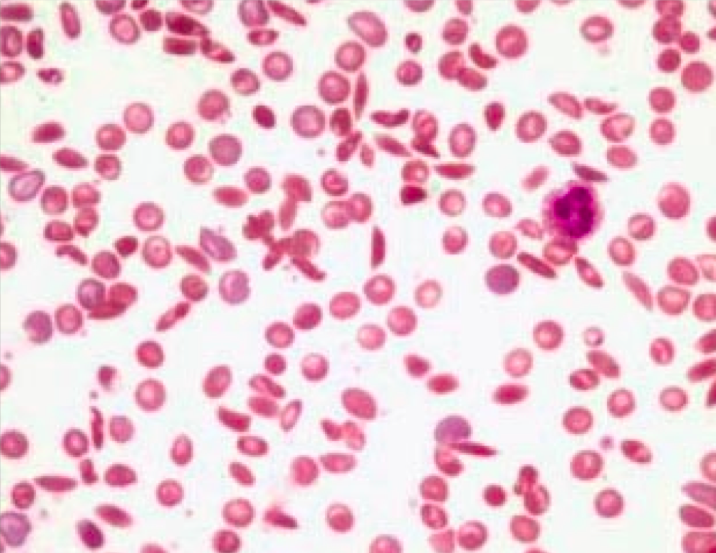
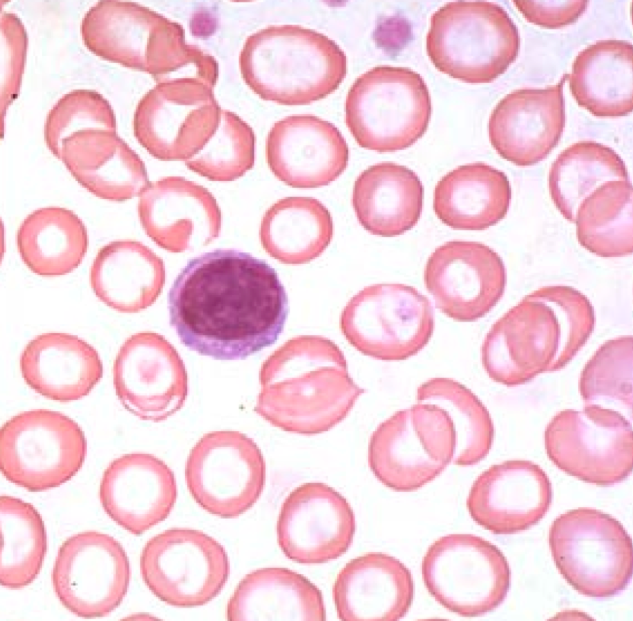
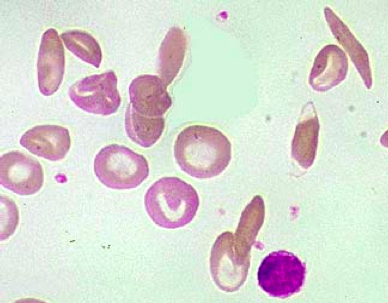

A 38-year-old woman visits her gynecologist with a chief complaint of excessive menstrual bleeding. She has been feeling tired and dizzy but reports no pains, fever or weight loss. Her grandparents came to the US from Italy. She is a vegetarian, but eats eggs regularly. Pulse of 100. Conjunctival pallor is noted. No icterus and her spleen is not enlarged. Several large smooth muscle tumors of the uterus (benign leiomyomata) are palpated by the physician during the bimanual pelvic exam. Hct 28%, Hb 8.5g/dL, 3.73 x 10 RBC/mm, MCV 75. WBC and platelet counts are within reference range. The cervical Pap smear shows no abnormality. What would you likely see on peripheral blood smear of this patient?
Leiomyomatas inhibit contraction of the uterus and cause excessive menstrual bleeding. This can result in iron-deficiency anemia from blood loss. Iron-deficiency anemia on blood smear would present with small RBCs (microcytic anemia) and increased central pallor (hypochromasia)
A 26-year-old auto mechanic reports to the emergency room with pains in the lower back and both knees. He reluctantly admits to some previous episodes, but is otherwise uninformative. He denies any recent use of medications or drugs. Physical exam discloses pulse of 105, and temperature 37.5 C. There is mild scleral icterus.The chest is clear and palpation of the abdomen shows no liver or spleen enlargement. HCT 24%, Hb 8.0 gm/dL, RBC count 3.46 x 106/mm3, WBC 8,000/mm3. WBC differential count: 35% segs, 2% bands, 1% monocytes, 4% eosinophils and 58% lymphocytes. A reticulocyte count is 4.5%. The platelet count is 550,000/ mm3. His peripheral blood smear is shown below. Why does this patient not have an enlarged spleen?
This patient most likely has a hemolytic anemia, note the scleral icterus from hemolysis and elevation in reticulocytes from bone marrow trying to compensate. The peripheral blood smear shows sickle cell anemia. Repeated vaso-occlusion of the spleen causes autoinfarction of the spleen.
A 30-year-old women on civilian assignment in Central Africa has lost her appetite. She recently recovered from a fever and had taken several antibiotics and an antimalarial. Physical exam shows a pronounced scleral icterus. The spleen in slightly enlarged. Hb 10 g/dL, MCV 80 fL, MCHC 29 g/dL. Manual retic count 8%. Hemosiderin is noted. What are the two major possibilities of this patient’s condition?
She is showing symptoms of intravascular hemolysis. This can be caused by G6PD and immunologic hemolysis.
A 68-year-old retired officer complained of increasingly severe low back pain that had begun to awaken him at night. His wife claimed he has lost about 10 pounds in the last few months. History taking revealed recent onset of a dry cough and some difficulty with urination. As the disease progressed, this patient suffered respiratory failure after repeated episodes of pleural effusions. A firm nodular mass was palpated in the prostate gland during digital rectal exam. HCT 30 %, Hb 9.8 gm/dL, RBC count 3.36 X 106/mm3; WBC 4,500 with 58% segs, 8% bands, 32% lymphocytes and 2% monocytes. > 2 nucleated RBCs/100 WBCs. A chest film shows several small subpleural densities and a minimal pleural effusion. What is most likely causing his condition?
Metastatic carcinoma from the prostate going to the bone marrow and causing the bone marrow to push out immature leukocytes.

A 20-year-old recruit from Nebraska is seen in the clinic for frequent nosebleeds and easy bruising. He feels “good” otherwise but physical examination reveals conjunctival pallor and ecchymoses on his arms and legs. A careful history reveals no prior infection or history of drug ingestion. He worked on his family’s farm prior to enlistment. Hb 6.2 g/dL, MCV 92 fl, MCHC 33%, RBC count 2.3 x 10 / mm , total WBC count 1500/ mm WBC differential count: 2% bands, 32% neutrophils, 62% lymphs, 4% monos. Manual reticulocytes 0.5%. Platelet count 19,000/ mm3. What can cause this condition?
This kid has aplastic anemia. You need to think about drug history, exposure to chemicals (benzene), radiation and infections (parvovirus, EBV and HIV)
A 54-year-old accountant complains of increasing dyspepsia and a “sore tongue”. She has suffered mild post-prandial “heartburn” for several years. Family history includes a maternal uncle who died of gastric cancer and a maternal grandmother who had “thyroid problems”. Physical exam discloses a pale, mildly obese woman in no acute distress. The skin and sclera have a faint yellow coloration. The spleen tip is barely palpable, the liver is not enlarged. Neurological exam demonstrates a loss of vibratory sense in the legs with diminished strength bilaterally. HCT 27%, MCV 117 fL, RBC 2.3 x 10 /mm , WBC 4,600 /mm . What is causing his condition?
He has megaloblastic anemia. This can be caused by folate deficiency, B12 deficiency (from autoimmune gastritis, alcoholics and vegans).
What is a general rule of thumb when analyzing bone marrow biopsy in a patient with anemia?
Bone marrow should be 50/50 hematopoietic cells and fat.

What type of anemia are you thinking of when a patient has splenomegaly?
Hemolytic anemia
RBC shape variation
Poikilocytosis
RBC size variation
Anisocytosis
What do you know if you can spot platelets visually on the blood smear?
The patient likely has normal platelet levels and is not anemic from a thrombocytopenia
What is your differential for this condition? How do you differentiate between these conditions?
This is a microcytic, hypochromic anemia. Iron deficiency anemia presents as microcytic, hypochromic anemia, and transferrin will be high, ferritin will be low, serum iron will be low and % saturation will be low. Thalassemia also presents as microcytic, hypochromic anemia, but has less variation in size (lower RDW) than iron-deficiency anemia. Anemia of chronic disease also presents as microcytic, hypochromic anemia, but will have increased ferritin, decreased TIBC, decrease serum iron and decreased % saturation. Lead poisoning also presents as a microcytic, hypochromic anemia.

How can a bone marrow biopsy help to tell you if a patient has iron-deficiency anemia?
A normal biopsy will appear like the image below when stained with Prussian blue, showing that Fe is present in the marrow.

What happens to the reticulocyte count in people with iron-deficiency anemia?
It does not elevate.
What are causes of intravascular hemolysis?
Intrinsic damage (G6PD deficiency) and extrinsic damage (mechanical heart valve)
When do you see intramedullary hemolysis?
Megaloblastic anemia. This is because the cells are being destroyed and mutated in the marrow before they are ever released.
What does this cell mean to you?

Marrow stress from hemolytic syndromes or metastatic cancers. This is a nucleated red cell that is released by the marrow from stress.
What promotes formation of the cell indicated below?
Low pH, low oxygen and dehydration all cause stress on Hgb to become deoxygenated. In sickle cell, the deoxygenated HbS come together to polymerize and form sickle cells.
How do you test for sickle cell disease?
Metabisulfite test. Metabisulfite consumes oxygen in the blood and causes sickling.

How could you use electrophoresis to determine the state of a patient with sickle cell disease?
Sickle cell trait with thalassemia = HbSA, sickle cell carrier = HbAS, sickle cell disease = HbSS, HbSC
What is better than having sickle cell trait, but still having sickle cell?
Hb SA: sickle cell trait w/ thalassemia. Thalassemia decreases globin production = less Hgb = less aggregation of sickle cells = less clinical symptoms.
Would you rather have HbSC or HbAS?
When you have HbSC you have increased outflow of water from RBCs and this promotes dehydration. Dehydration increases sickling in this condition.
Rank the types of sickle cell disease from least symptomatic to most symptomatic
Hb SA > Hb AS > Hb SC > Hb SS
Why do you want to keep sickle cell patients as healthy as possible?
Inflammation causes expression of adhesion molecules on the surface of RBCs. This causes really sticky cells that are irreversibly sickled. These go on to cause thrombosis of small blood vessels.
